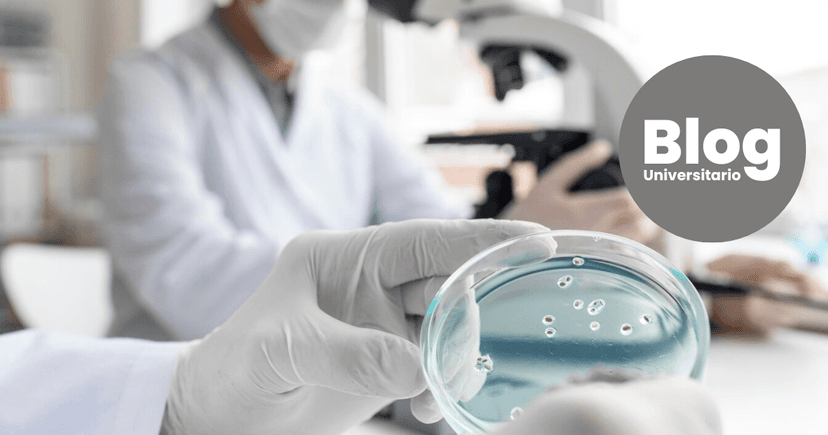
Imagen de portada de ¿Por qué estudiar Laboratorio Clínico?

Cada vez son más las personas que estudian una carrera corta, que a su vez les permita trabajar durante el tiempo de preparación o bien, justo al finalizarla.
Queremos compartirte detalles sobre la carrera de Laboratorio Clínico, es un área muy requerida por el Mercado Laboral actualmente y lo seguirá siendo en los próximos años.
De acuerdo con el último estudio de la Escuela de Economía de la UCR. Microbiología en todos sus niveles es una de las 5 carreras que no tienen saturación de mercado.
Las áreas de Microbiología y Laboratorio Clínico constituyen el segundo puesto de mayor demanda por las empresas
¿Dónde estudiar Laboratorio Clínico?
El Instituto Parauniversitario PLERUS, además de ser de las pocas opciones en el país que brindan esta carrera, cuentan con su plan de estudio en grado de Diplomado.
¿Qué hace un profesional en el Laboratorio Clínico?
Los estudiantes graduados de PLERUS serán capaces de ubicarse en posiciones laborales que les permita ser competentes en las siguientes destrezas:
- Obtener muestras biológicas de rutina tales como son sangre, orina y heces.
- Preparar y rotular adecuadamente muestras biológicas.
- Participar en la realización de exámenes variados del laboratorio clínico, bajo la supervisión de un profesional microbiólogo químico clínico.
- Preparar reactivos de laboratorio.
- Preparar medios de cultivo.
- Gestionar cristalería de uso de laboratorio.
- Utilizar eficientemente el equipo de laboratorio.
¿Dónde trabaja un graduado de esta carrera?
La formación del profesional le permite trabajar con la CCSS, laboratorios privados, enseñanza, investigación, industria y empresas que elaboran dispositivos médicos.
Actualmente el Instituto Parauniversitario PLERUS se encuentra en matrícula extraordinaria.
¿Porqué elegir PLERUS?
Esta Institución cuenta con un exclusivo laboratorio clínico/académico que se caracteriza por sus avanzados equipos médicos, asegurado así un elevado conocimiento, familiarización tecnológica y desarrollo de capacidades en sus graduados.
- Oferta de carreras cortas para la formación de profesionales en los diversos campos del saber, bajo estrictos y elevados estándares de calidad.
- Profesores con amplia experiencia docente y profesional
- Aulas equipadas con equipos audiovisuales
- Financiamiento y convenios empresariales disponibles
- Convenio con la Universidad Libre de Costa Rica (ULICORI)
El Instituto Parauniversitario Plerus ha establecido alianzas estratégicas con diferentes instituciones del Estado y privadas, cuyos convenios otorgan descuentos en las materias a personas asociadas, afiliadas, funcionarias, y a sus familiares (padre, madre, hermanos, cónyuge e hijos).
PLERUS, como parte de su proyecto educativo, también coloca a disposición de los interesados y estudiantes el financiamiento en tractos mensuales hasta por 6 meses, entre otros beneficios. Ingresá AQUÍ para conocer más sobre la carrera de Laboratorio Clínico y realizar todas tus consultas.









.png&w=256&q=75)